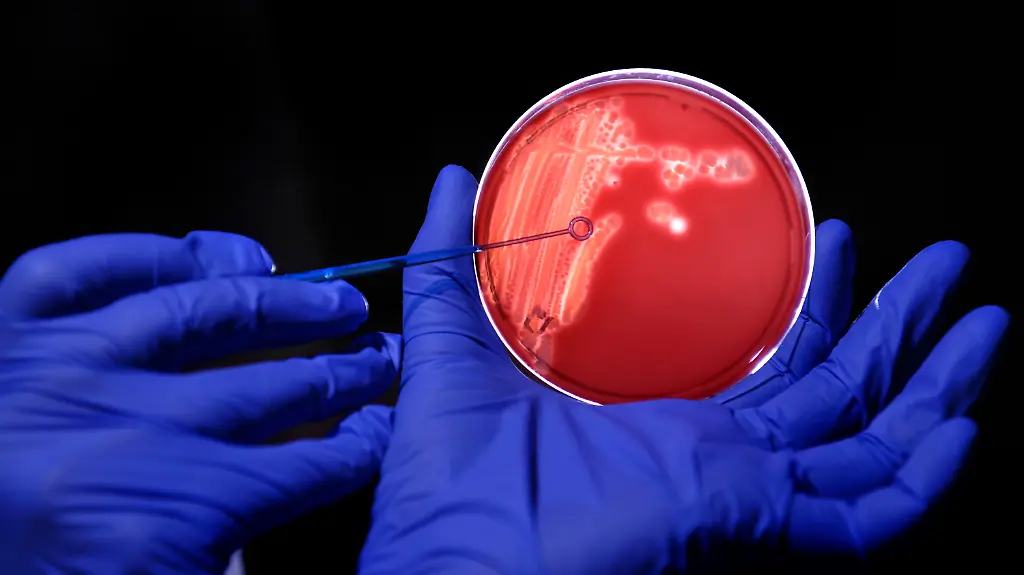
AP110525028244

Immunabwehr wird ausgetrickstDarmbakterien helfen Viren
Harmlose Bakterien im Darm ermöglichen es krank machenden Viren, der Immunabwehr des Körpers unerkannt zu entgehen. Wie Forscher belegen, bedecken sich die Viren mit bakteriellen Eiweißstückchen, um die Abwehrfunktionen des Immunsystems unterdrücken.
Bislang gingen Fachleute davon aus, dass Bakterien im Darm das Immunsystem "trainieren" und den Körper vor Infektionen mit Pilzen, Viren oder schädlichen Bakterien schützen. US-Wissenschaftler widerlegen diese These jetzt. Ihre überraschenden Untersuchungsergebnisse zweier Studien mit Mäusen stellen sie im Journal "Science" vor.
Melissa Kane und ihre Mitarbeiter von der University of Chicago (US-Staat Illinois) experimentierten mit dem Maus-Mammatumorvirus (MMTV). Dieses Virus wird mit der Milch von den Müttern auf den Nachwuchs übertragen und infiziert die Tiere dann über den Darm. In einem Versuch behandelten die Wissenschaftler nun schwangere Mäuse mit Antibiotika, um ihre Darmbakterien zu töten. Es zeigte sich, dass der Nachwuchs der Tiere später keine Anzeichen einer Infektion zeigte. So fanden sich weder Viren in der Milz noch Antikörper gegen die Viren im Blut. Die Viren, folgern die Forscher, benötigen für eine erfolgreiche Infektion die Hilfe der Darmbakterien.
Weitere Versuche zeigten, dass MMTV an ein Protein bindet, die normalerweise auf der Zellwand von Bakterien zu finden ist. Dieses Lipopolysaccharid (LPS) wiederum bindet an ein Molekül namens TLR4 (Toll-like Rezeptor 4) auf der Oberfläche von weißen Blutkörperchen. Dadurch wird ein Signalmolekül aktiviert (Interleukin 10), das schließlich die Immunreaktion unterdrückt – das Virus kann ungehindert in die Zellen eindringen und eine Infektion hervorrufen.
Erst Antibiotika, dann Polioviren
Zu ganz ähnlichen Ergebnissen kamen die Forscher um Sharon Kuss vom University of Texas Southwestern Medical Center (Dallas/US-Staat Texas). Sie hatten ebenfalls Mäuse mit Antibiotika behandelt und ihnen dann Polioviren verabreicht. Diese Mäuse erkrankten nun viel seltener als solche, deren Darmflora intakt war. Dieses Experiment wiederholten die Forscher mit einem Reovirus und kamen zu dem gleichen Resultat. Auch diese beiden Virustypen waren mit Hilfe des bakteriellen Lipopolysaccharids der Immunabwehr entgangen, zeigten die weiteren Experimente.
Kuss und ihre Mitarbeiter vermuten, dass das LPS die Viren möglicherweise näher an die Zellen des Darms bringt und ihnen so das Eindringen in die Zellen erleichtert. Das sei ein besonders eindrucksvolles Beispiel für die gegenseitige Abhängigkeit von Viren, Bakterien und dem Darm, kommentiert Herbert Virgin von der Washington University School of Medicine (St. Louis/US-Staat Missouri) die Ergebnisse. Künftig müssten Virologen auch über Darmbakterien nachdenken, wenn sie die Infektiösität von bestimmten Viren untersuchten.